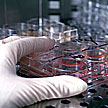

En Estados Unidos:
Y la vida será sintética
El hombre que lidera los esfuerzos en el sector privado para descifrar el genoma humano dice haber dado un paso importante para crear vida sintética en el laboratorio.
En un artículo que publica la revista especializada Science, el científico estadounidense Craig Venter, informa que su equipo logró producir con éxito una bacteria diseñada, a partir de un genoma transplantado.
Aunque pueda sonar a una historia salida de una película de Frankenstein, Venter cree que esto podría abrir el camino para la creación de una amplia gama de organismos.
Con éstos, pretende contribuir a la solución de muchas de las enfermedades del planeta: biocombustibles más ecológicos, organismos con la capacidad de limpiar aguas contaminadas, incluso herramientas orgánicas capaces de absorber los gases de efecto invernadero.
Microbios diseñados
El plan, en última instancia, consiste en arrojar una porción de cromosomas producidos artificialmente, algunas proteínas y otros componentes celulares básicos en un caldo primordial y sentarse a observar cómo un primitivo microbio salta espontáneamente a la vida.
Para eso todavía falta un largo camino, como el mismo Venter lo acepta, aunque en su informe de investigación, anuncia que ha dado un paso clave hacia ese objetivo: transplantar un genoma completo de una célula bacterial a otra.
Esencialmente, esto significa arrebatar el cuerpo de una forma de vida e invadirlo con un nuevo código genético, lo cual -según aduce- es una herramienta vital para probar los cromosomas artificiales o ADN que proyecta crear.
"El cromosoma nativo de una especie diferente fue insertado a través de la membrana externa de la célula huésped, perteneciente a otra especie", explicó Venter a la BBC.
"Después de varios días de crecimiento y división celular, observamos que el cromosoma original de la célula había desaparecido y teníamos ahora células que contenían sólamente el cromosoma transplantado", añadió.
Temores
Hay quienes están preocupados por los trabajos del científico estadounidense.
Algunos temen que la tecnología pueda ser usada para la elaboración de armas biológicas o simplemente que algo imprevisible pueda emerger de sus laboratorios.
Desde otro sector, hay quienes creen que los esfuerzos del instituto que dirige Venter para patentar la técnica pueda restringir los avances de la ciencia.
"En los últimos años hemos estados desarrollando nuevas técnicas y perspectivas que no existían en un campo que tampoco existía antes", se defiende el científico.
"El Instituto Venter y la compañía Synthetic Genomics sólo hacen lo mismo que otras instituciones, esto es patentar estas técnicas originales", concluye.
Neil Bowdler
BBC, Ciencia y Tecnología.
|
|